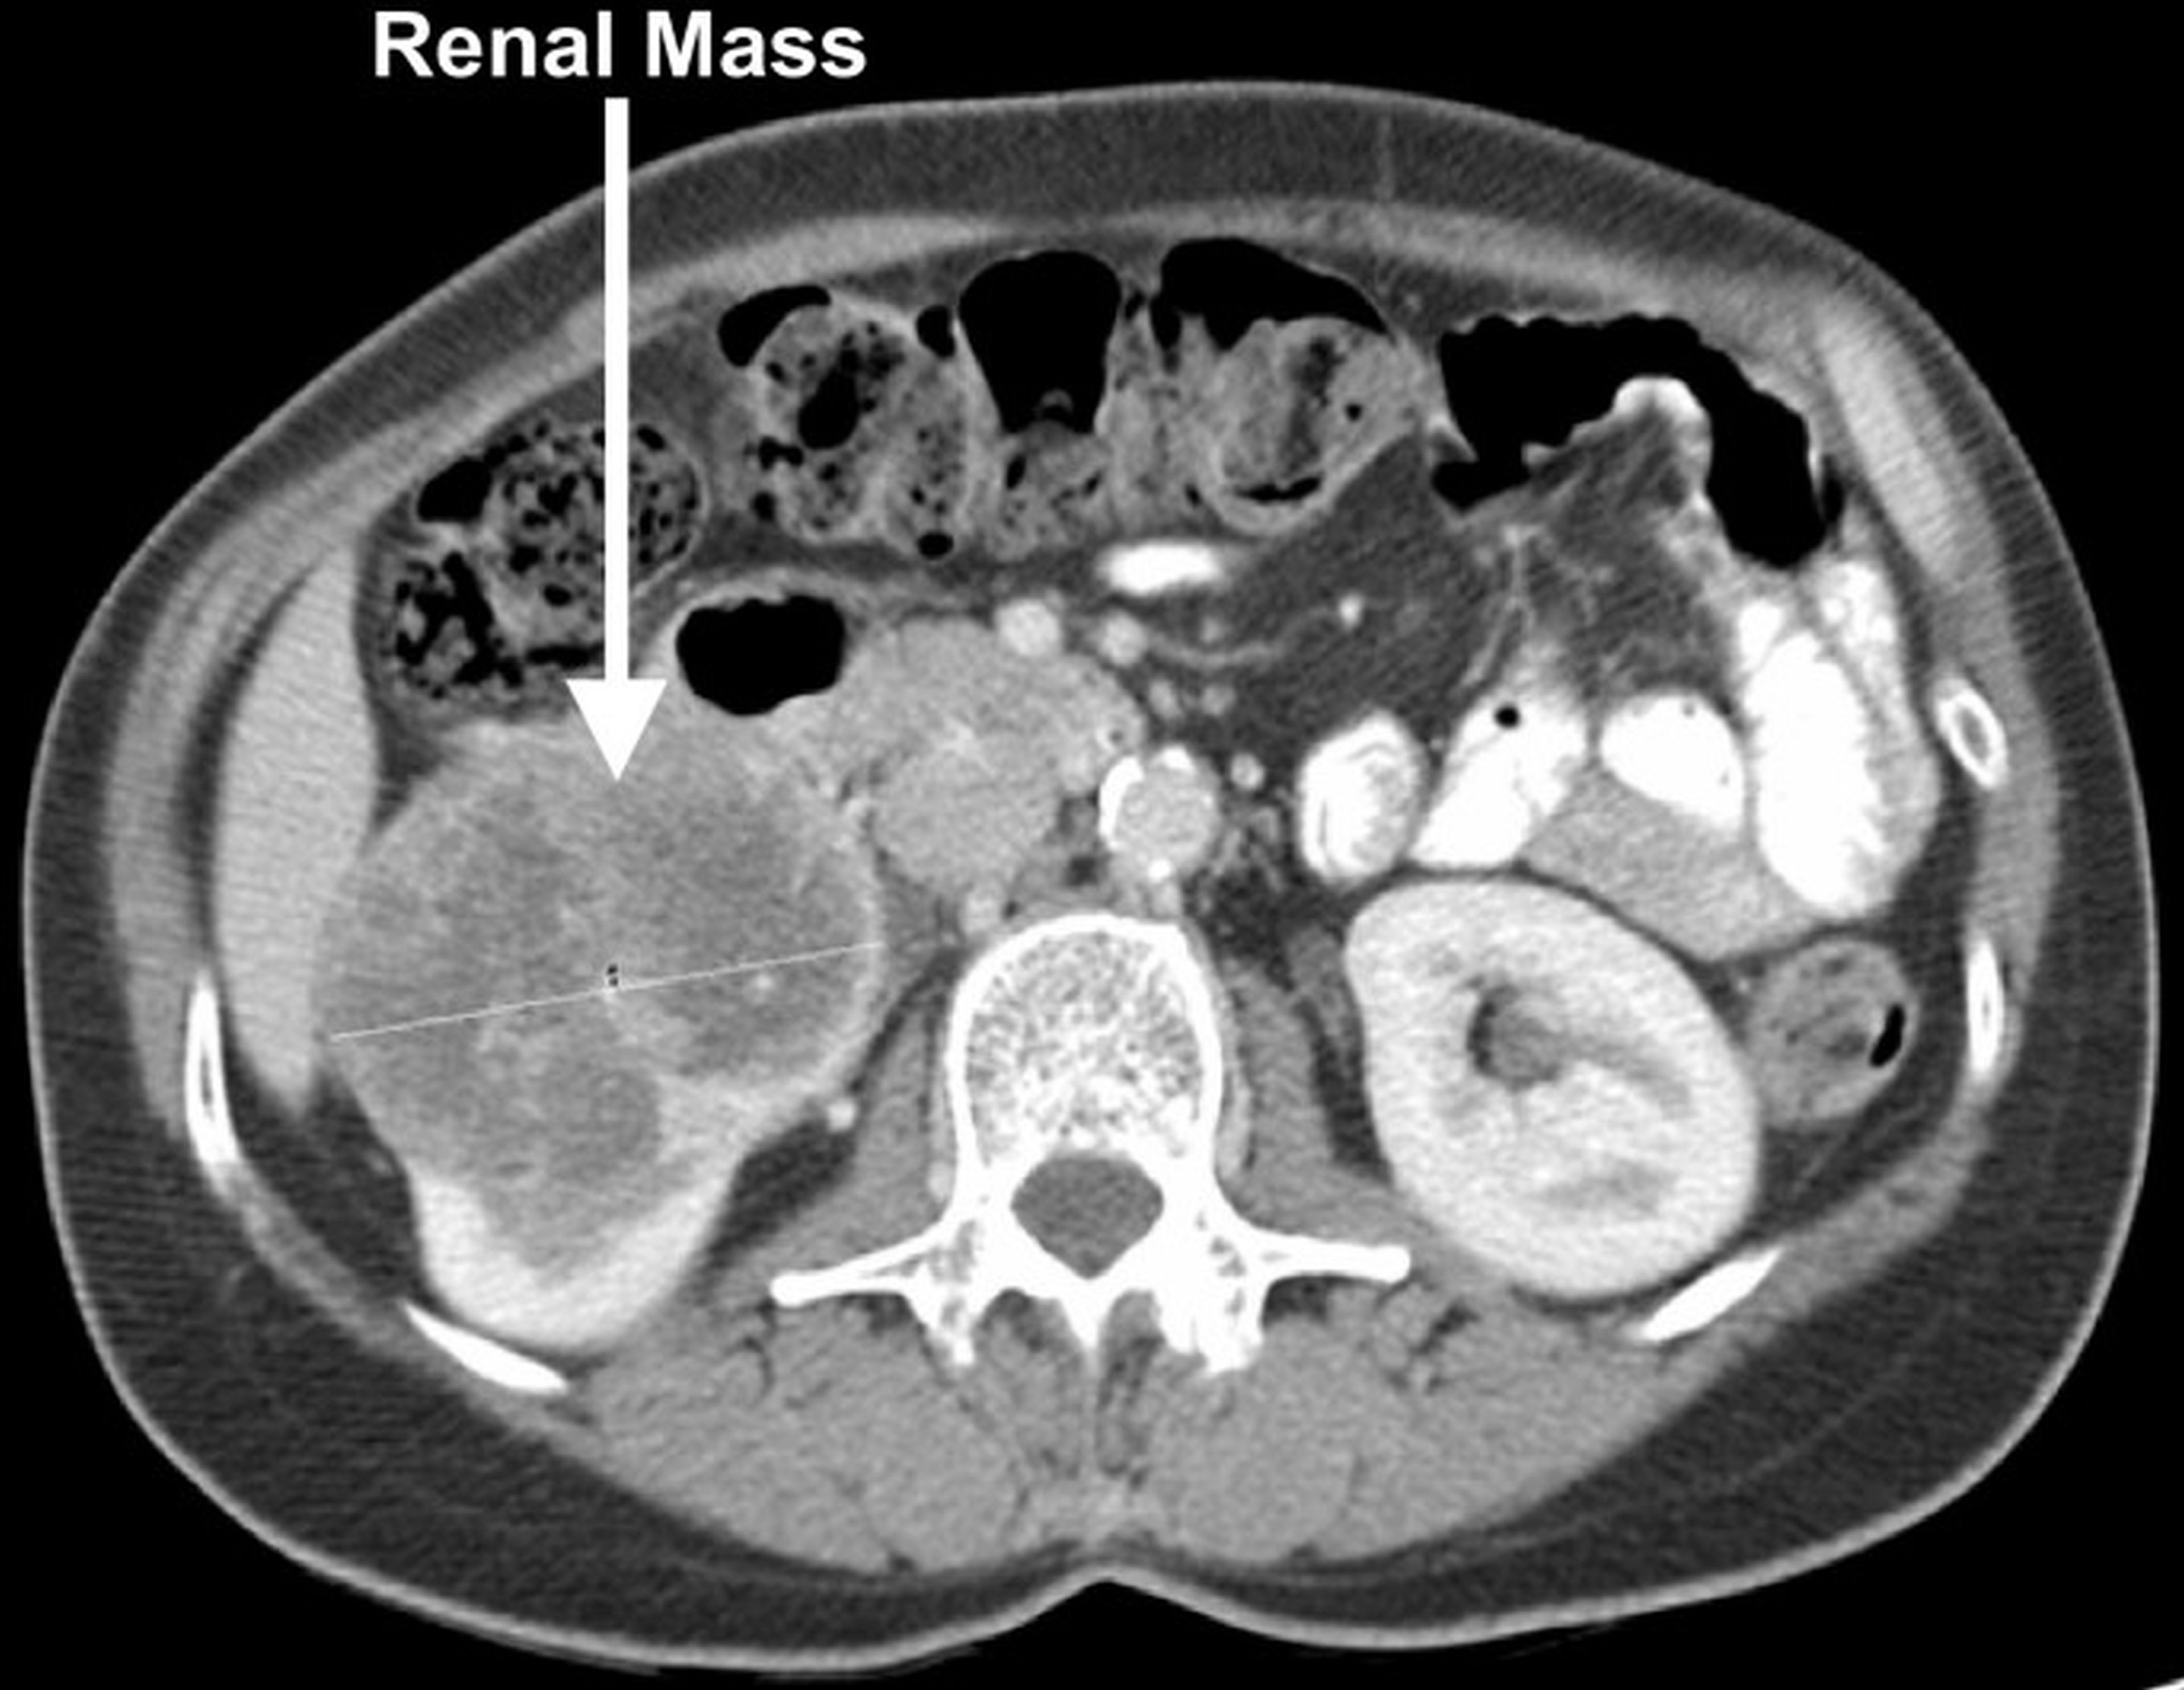

KIDNEY CANCER
 |
 |
|
 |
The kidneys filter the blood and the waste products are transferred through the ureters to be stored in the bladder as urine. Urine is then discharged through the urethra to empty the bladder. Kidneys play a vital role in production of blood cells from bone marrow, maintenance of blood pressure and also in Vit-D metabolism.
There are several types of cancer that can affect the kidneys. Renal cell carcinoma (RCC), is the most common form and accounts for approximately 85% of all kidney cancers. In RCC, malignant cells develop in the lining of the kidney's tubules and typically grow into a mass called a tumour. The earlier kidney tumours are discovered, the better a patient's chances for survival. Tumours discovered at an early stage often respond well to treatment. Survival rates in such cases are high. Tumours that have grown large or spread to other parts of the body are much more difficult to treat and present a greatly increased risk to patients life.
Patients who have loin pain, blood in urine or a vagulely felt lump in upper abdomen are likely to have kidney cancer. It is important to consult a nearby doctor to get ultrasound scan followed by a specialist consultation to decide on further course of action.


